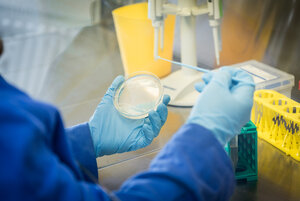
Labor für Analytik der Lebensmittel und Bedarfsgegenstände

Hygieneschutz und Hardware-Spenden
26.05.2020, 15:13 Uhr
Im Mai gab es wieder einige Initiativen in Folge der Coronakrise an der Beuth Hochschule. Engagierte Mitglieder der Hochschule produzierten neben Desinfektionsmittel auch Plexiglaswände für Büros und Servicestellen. Studierenden im digitalen Semester wurde mit Materialspenden geholfen. mehr…